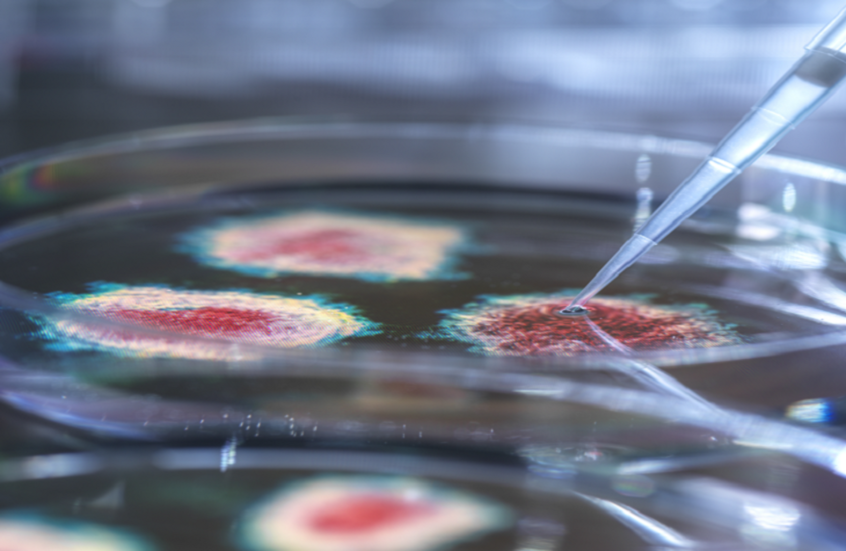
أخصائي مناعة ينصح بأول خطوة عند الإصابة بأعراض فيروس "كوكساكي"

Stories
-
![مونديال 2026]()
مونديال 2026
RT STORIES
النرويج تكتب التاريخ وتحتفل بأسلوب "الفايكينغ" بعد إسقاط السنغال (فيديو)
![النرويج تكتب التاريخ وتحتفل بأسلوب "الفايكينغ" بعد إسقاط السنغال (فيديو)]() #اسأل_أكثر #Question_More
#اسأل_أكثر #Question_MoreRT STORIES
الجزائر تقلب الطاولة على الأردن وتفوز 2-1 في مونديال 2026
![الجزائر تقلب الطاولة على الأردن وتفوز 2-1 في مونديال 2026]() #اسأل_أكثر #Question_More
#اسأل_أكثر #Question_MoreRT STORIES
ليفربول يفاجئ صلاح بعد ليلة تاريخية مع منتخب مصر في مونديال 2026
![ليفربول يفاجئ صلاح بعد ليلة تاريخية مع منتخب مصر في مونديال 2026]() #اسأل_أكثر #Question_More
#اسأل_أكثر #Question_MoreRT STORIES
ما المنتخبات المتأهلة إلى دور الـ32 من كأس العالم 2026؟
![ما المنتخبات المتأهلة إلى دور الـ32 من كأس العالم 2026؟]() #اسأل_أكثر #Question_More
#اسأل_أكثر #Question_MoreRT STORIES
هالاند يكتب التاريخ.. أرقام قياسية جديدة في كأس العالم 2026
![هالاند يكتب التاريخ.. أرقام قياسية جديدة في كأس العالم 2026]() #اسأل_أكثر #Question_More
#اسأل_أكثر #Question_MoreRT STORIES
بعد ثنائية في شباك العراق.. مبابي يواصل التحطيم ويقترب من ميسي في صدارة تاريخية
![بعد ثنائية في شباك العراق.. مبابي يواصل التحطيم ويقترب من ميسي في صدارة تاريخية]() #اسأل_أكثر #Question_More
#اسأل_أكثر #Question_MoreRT STORIES
النرويج تحسم الإثارة أمام السنغال 3-2 في مباراة درامية
![النرويج تحسم الإثارة أمام السنغال 3-2 في مباراة درامية]() #اسأل_أكثر #Question_More
#اسأل_أكثر #Question_MoreRT STORIES
نبض اليوم الـ13 من المونديال.. الجولة الثانية تقترب من النهاية
![نبض اليوم الـ13 من المونديال.. الجولة الثانية تقترب من النهاية]() #اسأل_أكثر #Question_More
#اسأل_أكثر #Question_MoreRT STORIES
فرنسا تكتسح العراق بثلاثية وتحجز مقعدها في دور الـ32
![فرنسا تكتسح العراق بثلاثية وتحجز مقعدها في دور الـ32]() #اسأل_أكثر #Question_More
#اسأل_أكثر #Question_MoreRT STORIES
4 منتخبات تحسم تأهلها رسميا إلى دور الـ32 في مونديال 2026
![4 منتخبات تحسم تأهلها رسميا إلى دور الـ32 في مونديال 2026]() #اسأل_أكثر #Question_More
#اسأل_أكثر #Question_MoreRT STORIES
ميسي يهز شباك النمسا ويصبح الهداف التاريخي لبطولات كأس العالم
![ميسي يهز شباك النمسا ويصبح الهداف التاريخي لبطولات كأس العالم]() #اسأل_أكثر #Question_More
#اسأل_أكثر #Question_MoreRT STORIES
نهاية حقبة.. كورتوا يقترب من وداع المنتخب البلجيكي
![نهاية حقبة.. كورتوا يقترب من وداع المنتخب البلجيكي]() #اسأل_أكثر #Question_More
#اسأل_أكثر #Question_MoreRT STORIES
بعد الانتقادات التي طالته.. مايكل أوين يدافع عن كريستيانو رونالدو
![بعد الانتقادات التي طالته.. مايكل أوين يدافع عن كريستيانو رونالدو]() #اسأل_أكثر #Question_More
#اسأل_أكثر #Question_MoreRT STORIES
رد فعل محمد صلاح عند استبداله أمام نيوزيلندا (فيديو)
![رد فعل محمد صلاح عند استبداله أمام نيوزيلندا (فيديو)]() #اسأل_أكثر #Question_More
#اسأل_أكثر #Question_MoreRT STORIES
ألمانيا تتلقى ضربة قاسية في مونديال 2026
![ألمانيا تتلقى ضربة قاسية في مونديال 2026]() #اسأل_أكثر #Question_More
#اسأل_أكثر #Question_MoreRT STORIES
بعد الفوز التاريخي على نيوزيلندا.. منتخب مصر يقفز في تصنيف "الفيفا"
![بعد الفوز التاريخي على نيوزيلندا.. منتخب مصر يقفز في تصنيف "الفيفا"]() #اسأل_أكثر #Question_More
#اسأل_أكثر #Question_MoreRT STORIES
هل يسقط رقم كلوزه الليلة؟.. ميسي على موعد مع التاريخ في مواجهة النمسا
![هل يسقط رقم كلوزه الليلة؟.. ميسي على موعد مع التاريخ في مواجهة النمسا]() #اسأل_أكثر #Question_More
#اسأل_أكثر #Question_MoreRT STORIES
محرز يعود للواجهة.. تعديلات في معظم المراكز بتشكيلة منتخب الجزائر أمام الأردن
![محرز يعود للواجهة.. تعديلات في معظم المراكز بتشكيلة منتخب الجزائر أمام الأردن]() #اسأل_أكثر #Question_More
#اسأل_أكثر #Question_MoreRT STORIES
"مزق سروالي وسقط على منطقة حساسة في جسدي".. لاعب نيوزيلندا ينتقد مدافع المنتخب المصري
!["مزق سروالي وسقط على منطقة حساسة في جسدي".. لاعب نيوزيلندا ينتقد مدافع المنتخب المصري]() #اسأل_أكثر #Question_More
#اسأل_أكثر #Question_MoreRT STORIES
مونديال 2026.. الأردن والجزائر بين "أكون أو لا أكون"
![مونديال 2026.. الأردن والجزائر بين "أكون أو لا أكون"]() #اسأل_أكثر #Question_More
#اسأل_أكثر #Question_MoreRT STORIES
منتخب الجزائر يتعرض لضربة موجعة قبل لقاء الأردن
![منتخب الجزائر يتعرض لضربة موجعة قبل لقاء الأردن]() #اسأل_أكثر #Question_More
#اسأل_أكثر #Question_More![مونديال 2026]() مونديال 2026
مونديال 2026
-
![اتفاق أمريكي إيراني لوقف الحرب على جميع الجبهات]()
اتفاق أمريكي إيراني لوقف الحرب على جميع الجبهات
RT STORIES
طهران وواشنطن تشكلان 4 مجموعات عمل بعد مفاوضات سويسرا
![طهران وواشنطن تشكلان 4 مجموعات عمل بعد مفاوضات سويسرا]() #اسأل_أكثر #Question_More
#اسأل_أكثر #Question_MoreRT STORIES
أردوغان يقدم لبزشكيان دعم تركيا لإنهاء المفاوضات بين إيران وأمريكا "بشكل سلمي"
![أردوغان يقدم لبزشكيان دعم تركيا لإنهاء المفاوضات بين إيران وأمريكا "بشكل سلمي"]() #اسأل_أكثر #Question_More
#اسأل_أكثر #Question_MoreRT STORIES
ترامب حول رفض إسرائيل سحب القوات من لبنان: أعمل على حل المشاكل بما فيها تلك التي تتعلق بنتنياهو
![ترامب حول رفض إسرائيل سحب القوات من لبنان: أعمل على حل المشاكل بما فيها تلك التي تتعلق بنتنياهو]() #اسأل_أكثر #Question_More
#اسأل_أكثر #Question_MoreRT STORIES
ترامب عن إيران: طالما أنهم يحترموننا.. لا أريد استخدام كلمة "خوف" لأنها غير مناسبة
![ترامب عن إيران: طالما أنهم يحترموننا.. لا أريد استخدام كلمة "خوف" لأنها غير مناسبة]() #اسأل_أكثر #Question_More
#اسأل_أكثر #Question_MoreRT STORIES
قاليباف: إدارة مضيق هرمز لن تعود إلى ما كانت عليه قبل الحرب وتم الإفراج عن 12 مليار دولار من أصولنا
![قاليباف: إدارة مضيق هرمز لن تعود إلى ما كانت عليه قبل الحرب وتم الإفراج عن 12 مليار دولار من أصولنا]() #اسأل_أكثر #Question_More
#اسأل_أكثر #Question_MoreRT STORIES
مسقط وطهران تبحثان ترتيبات مضيق هرمز وضمان أمن الملاحة فيه
![مسقط وطهران تبحثان ترتيبات مضيق هرمز وضمان أمن الملاحة فيه]() #اسأل_أكثر #Question_More
#اسأل_أكثر #Question_MoreRT STORIES
"تسنيم" تكشف أبرز النقاط حول الجولة الأولى من المفاوضات: وحدة لمراقبة النزاع في لبنان بمشاركة إيران
!["تسنيم" تكشف أبرز النقاط حول الجولة الأولى من المفاوضات: وحدة لمراقبة النزاع في لبنان بمشاركة إيران]() #اسأل_أكثر #Question_More
#اسأل_أكثر #Question_MoreRT STORIES
قاليباف: إيران لن تتخلى عن ملف سيادة لبنان حتى استكمال تثبيت وحدته وسلامة أراضيه والوصول إلى النتيجة
![قاليباف: إيران لن تتخلى عن ملف سيادة لبنان حتى استكمال تثبيت وحدته وسلامة أراضيه والوصول إلى النتيجة]() #اسأل_أكثر #Question_More
#اسأل_أكثر #Question_MoreRT STORIES
همتي: إذا كانت أسعار وجودة المنتجات الأمريكية أفضل فلا مانع من شرائها.. لا وجود لاعتبارات سياسية
![همتي: إذا كانت أسعار وجودة المنتجات الأمريكية أفضل فلا مانع من شرائها.. لا وجود لاعتبارات سياسية]() #اسأل_أكثر #Question_More
#اسأل_أكثر #Question_MoreRT STORIES
بن غفير يهدد بتحويل بيروت إلى بيت حانون ثانية ويطالب بإنهاء التهدئة (فيديو)
![بن غفير يهدد بتحويل بيروت إلى بيت حانون ثانية ويطالب بإنهاء التهدئة (فيديو)]() #اسأل_أكثر #Question_More
#اسأل_أكثر #Question_MoreRT STORIES
شهباز شريف يعلن نجاح الاجتماع الأول لمفاوضات واشنطن وطهران
![شهباز شريف يعلن نجاح الاجتماع الأول لمفاوضات واشنطن وطهران]() #اسأل_أكثر #Question_More
#اسأل_أكثر #Question_MoreRT STORIES
صادرات النفط الإيراني عبر هرمز تسجل أعلى مستوى منذ بداية النزاع
![صادرات النفط الإيراني عبر هرمز تسجل أعلى مستوى منذ بداية النزاع]() #اسأل_أكثر #Question_More
#اسأل_أكثر #Question_More![اتفاق أمريكي إيراني لوقف الحرب على جميع الجبهات]() اتفاق أمريكي إيراني لوقف الحرب على جميع الجبهات
اتفاق أمريكي إيراني لوقف الحرب على جميع الجبهات
-
![العملية العسكرية الروسية في أوكرانيا]()
العملية العسكرية الروسية في أوكرانيا
RT STORIES
القوات الأوكرانية تنسحب من أطراف قسطنطينوفكا تحت ضغط التقدم الروسي
![القوات الأوكرانية تنسحب من أطراف قسطنطينوفكا تحت ضغط التقدم الروسي]() #اسأل_أكثر #Question_More
#اسأل_أكثر #Question_MoreRT STORIES
مقتل خمسة أشخاص في هجوم صاروخي أوكراني على فورونيج
![مقتل خمسة أشخاص في هجوم صاروخي أوكراني على فورونيج]() #اسأل_أكثر #Question_More
#اسأل_أكثر #Question_MoreRT STORIES
الكرملين: بوتين سيبحث مع لوكاشينكو تهديدات زيلينسكي لبيلاروس
![الكرملين: بوتين سيبحث مع لوكاشينكو تهديدات زيلينسكي لبيلاروس]() #اسأل_أكثر #Question_More
#اسأل_أكثر #Question_MoreRT STORIES
كونستانتينوفكا.. العلم الروسي وراية النصر في شارع بريوبراجينسكايا
#اسأل_أكثر #Question_MoreRT STORIES
الدفاع الروسية: توجيه ضربات دقيقة لمواقع النفط والطاقة والمحروقات في أوكرانيا
![الدفاع الروسية: توجيه ضربات دقيقة لمواقع النفط والطاقة والمحروقات في أوكرانيا]() #اسأل_أكثر #Question_More
#اسأل_أكثر #Question_MoreRT STORIES
"مجرد دمية تقاتل حتى آخر أوكراني".. خبير نرويجي يوجه صفعة لزيلينسكي
!["مجرد دمية تقاتل حتى آخر أوكراني".. خبير نرويجي يوجه صفعة لزيلينسكي]() #اسأل_أكثر #Question_More
#اسأل_أكثر #Question_MoreRT STORIES
مسيرات "غيران-2" الانقضاضية توقع دماراً في مركز إمداد أوكراني ومخزن للمسيرات في خاركوف
#اسأل_أكثر #Question_More![العملية العسكرية الروسية في أوكرانيا]() العملية العسكرية الروسية في أوكرانيا
العملية العسكرية الروسية في أوكرانيا
-
فيديوهات
RT STORIES
موسكو.. غرس 27 مليون شجرة بدعم من "حديقة الذاكرة"
#اسأل_أكثر #Question_MoreRT STORIES
غزة.. الطائرات الإسرائيلية تستهدف سيارة في حي الرمال
#اسأل_أكثر #Question_MoreRT STORIES
ستاروبيلسك.. أطفال تحت الأنقاض
![ستاروبيلسك.. أطفال تحت الأنقاض]() #اسأل_أكثر #Question_More
#اسأل_أكثر #Question_MoreRT STORIES
النرويج.. إشعال نار بارتفاع 35 مترا احتفالا بالانقلاب الصيفي
#اسأل_أكثر #Question_MoreRT STORIES
غواتيمالا.. قصف بركاني تجاه سياح على سفح جبل فويغو
#اسأل_أكثر #Question_MoreRT STORIES
فانس وعراقجي في نفس الغرفة.. الكاميرات ترصد رد فعل نائب ترامب أثناء دخول وزير الخارجية الإيراني
![فانس وعراقجي في نفس الغرفة.. الكاميرات ترصد رد فعل نائب ترامب أثناء دخول وزير الخارجية الإيراني]() #اسأل_أكثر #Question_More
#اسأل_أكثر #Question_MoreRT STORIES
قوات مشاة البحرية الأمريكية والفلبينية تقتحم شاطئا ضمن تدريبات إنزال برمائي
![قوات مشاة البحرية الأمريكية والفلبينية تقتحم شاطئا ضمن تدريبات إنزال برمائي]() #اسأل_أكثر #Question_More
#اسأل_أكثر #Question_MoreRT STORIES
ناريندرا مودي يقود تجمعا جماعيا في كلكتا احتفالا باليوم العالمي لليوغا
![ناريندرا مودي يقود تجمعا جماعيا في كلكتا احتفالا باليوم العالمي لليوغا]() #اسأل_أكثر #Question_More
#اسأل_أكثر #Question_MoreRT STORIES
مظاهرات في عدن تطالب باستعادة دولة الجنوب وترفض الوصاية الخارجية
![مظاهرات في عدن تطالب باستعادة دولة الجنوب وترفض الوصاية الخارجية]() #اسأل_أكثر #Question_More
#اسأل_أكثر #Question_MoreRT STORIES
الجيش الروسي يدمر مستودع مسيرات ومعدات عسكرية أوكرانية في زابوروجيه
![الجيش الروسي يدمر مستودع مسيرات ومعدات عسكرية أوكرانية في زابوروجيه]() #اسأل_أكثر #Question_More
#اسأل_أكثر #Question_MoreRT STORIES
شاهد.. طيار شراعي علق بمظلته فوق رافعة بناء في الصين
![شاهد.. طيار شراعي علق بمظلته فوق رافعة بناء في الصين]() #اسأل_أكثر #Question_More
#اسأل_أكثر #Question_Moreفيديوهات
-
![الغطس.. روسيا تحسم ذهبية الفرق المختلطة في أوروبا]()
الغطس.. روسيا تحسم ذهبية الفرق المختلطة في أوروبا
RT STORIES
الغطس.. روسيا تحسم ذهبية الفرق المختلطة في أوروبا
![الغطس.. روسيا تحسم ذهبية الفرق المختلطة في أوروبا]() #اسأل_أكثر #Question_More
#اسأل_أكثر #Question_More
عبارات ينبغي على الأطباء تجنبها لتخفيف معاناة مرضاهم
وجدت دراسة حديثة أن العبارات التي يستخدمها الأطباء أثناء تواصلهم مع المرضى المصابين بأمراض خطيرة، يمكن أن تؤثر بشكل كبير على حالتهم العاطفية وقراراتهم العلاجية.

وأكد الباحثون أن بعض العبارات قد تثير القلق، وتدفع المرضى وأسرهم إلى الشعور بالعجز، ما يضعف قدرة الأطباء على اتخاذ قرارات مشتركة وفعالة مع المرضى.
لذلك، شدد الباحثون على ضرورة اعتماد "التواصل الرحيم" كجزء أساسي من عملية العلاج، وأوضحوا ما يجب تجنبه من كلمات واستخدام بدائل أكثر حساسية.
وقال الدكتور ليونارد بيري، أستاذ التسويق بجامعة "تكساس إيه آند إم"، إنه بالرغم من التقدم الكبير في علاج الأمراض الخطيرة مثل السرطان وقصور القلب المتقدم ومرض الرئة في مراحله النهائية، تظل بعض المشاعر مثل الخوف والقلق جزءا من تجربة المريض. وأضاف أن التحدي يكمن في كيفية التواصل بشكل يخفف من هذا القلق ويعزز من الثقة في العلاج.
وفي الدراسة، حدد فريق البحث مجموعة من العبارات التي يجب على الأطباء تجنبها تماما، مثل:
- "لا يوجد شيء آخر يمكننا القيام به".
- "لن تتحسن".
- "إيقاف العلاج الداعم".
- "ندور في حلقة مفرغة".
- "هل تريد منا أن نفعل كل شيء؟".
- "القتال" أو "المعركة".
- "لا أعرف لماذا انتظرت طويلا قبل الحضور".

روسيا.. نظام برمجي طبي جديد لتحسين عمليات جراحة العيون
- "ماذا كان أطباؤك الآخرون يفعلون/يفكرون؟".
وقال الباحثون إن مثل هذه العبارات تخلق مشاعر اليأس والضغط النفسي على المريض، كما قد تعيق من اتخاذ قرارات فاعلة بشأن العلاج.
وفي دراسة تتعلق برعاية مرضى السرطان، تبين أن العبارات مثل "لا داعي للقلق بشأن ذلك الآن"، و"أنت محظوظ، إنها المرحلة الثانية فقط"، تعتبر تقليلا غير لائق من المخاوف المشروعة للمريض.
وشدد الباحثون على أهمية أن يتعلم الأطباء كيف يختارون كلماتهم بعناية، بما يساعد في بناء علاقة ثقة مع المريض ويعزز من مشاركته في اتخاذ قرارات العلاج. وأوضحوا أن الأطباء يمكنهم تبني أساليب مثل: "ما هي أسئلتك لي؟" بدلا من السؤال التقليدي "هل لديك أي أسئلة؟"، ما يشجع المريض على التعبير عن اهتماماته ومخاوفه بشكل أكثر انفتاحا.
وعند الحديث عن "القتال" أو "المعركة"، يوصي الباحثون بأن يعبّر الطبيب عن الدعم المشترك بعبارات مثل: "سنواجه هذا التحدي معا"، ما يخلق شعورا بالطمأنينة والدعم الجماعي.
وأكد الباحثون على أن الإرشاد والتوجيه من الأطباء ذوي الخبرة له دور كبير في تعزيز مهارات التواصل، حيث يمكنهم مشاركة تجاربهم وتقديم نصائح حول الكلمات التي ينبغي تجنبها.
نشرت الدراسة في مجلة Mayo Clinic Proceedings.
المصدر: ميديكال إكسبريس
إقرأ المزيد

الخوف من العيادات الطبية.. أسباب نفسية خفية لدى البالغين
ذكرت أخصائية علم النفس الروسية ليليا غلادكيخ عدة أسباب تدفع بعض البالغين إلى الخوف من الأطباء وتجنب زيارة العيادات الطبية.

الجلوس يقتلنا!.. حل سهل لتحسين صحتك وتقليل خطر الوفاة المبكرة
أصبح أسلوب حياتنا اليومي، الذي يفرض علينا الجلوس لساعات طويلة سواء في المكاتب أو أمام شاشات التلفاز، أحد أكبر المسببات الرئيسية للأمراض المزمنة.

طبيب يؤكد على أهمية تناول الزبيب بانتظام
أكد الدكتور فلاديمير لوغينوف أخصائي أمراض الجهاز الهضمي، أنه يجب تناول الزبيب بانتظام لأنه يحتوي على فيتامينات وعناصر معدنية ومضادات أكسدة ضرورية لعمل أجهزة الجسم المختلفة.
أخصائي مناعة ينصح بأول خطوة عند الإصابة بأعراض فيروس "كوكساكي"
أكد أخصائي المناعة والأمراض المعدية الروسي فلاديسلاف جيمتشوغوف على ضرورة استشارة الطبيب عند الإصابة بأعراض فيروس "كوكساكي" كخطوة أولى.

مرض يتسلل إلى جسمك قبل سنوات من اكتشافه!
حذرت الخبيرة فيديريكا أماتي، رئيسة قسم التغذية في مستشفى زوي في مدينة ميلانو الإيطالية، من مرض قد يبدأ في التأثير على الجسم قبل سنوات من ظهور الأعراض.

خبيرة تقدم نصيحة للتخفيف من الهالات السوداء تحت العين
قدمت خبيرة في العناية بالبشرة نصيحتها الخاصة لمساعدة الأشخاص في تخفيف الهالات السوداء تحت العين.

العدو الخفي لصحة الأجيال الجديدة!
تسلط دراسة جديدة الضوء على أهمية التغذية الصحية خلال السنوات الأولى من حياة الطفل لحمايته من مخاطر صحية مستقبلية، مثل السكري وارتفاع ضغط الدم.

طبيبة تفند معتقدات خاطئة حول عقم الرجال
يبقى العقم عند الرجال على الرغم من التقدم الطبي الحديث، موضوعا محاطا بالعديد من الأوهام والصور النمطية، ما يخلق حواجز أمام الأزواج الذين يحلمون بإنجاب طفل.



























































































































































التعليقات